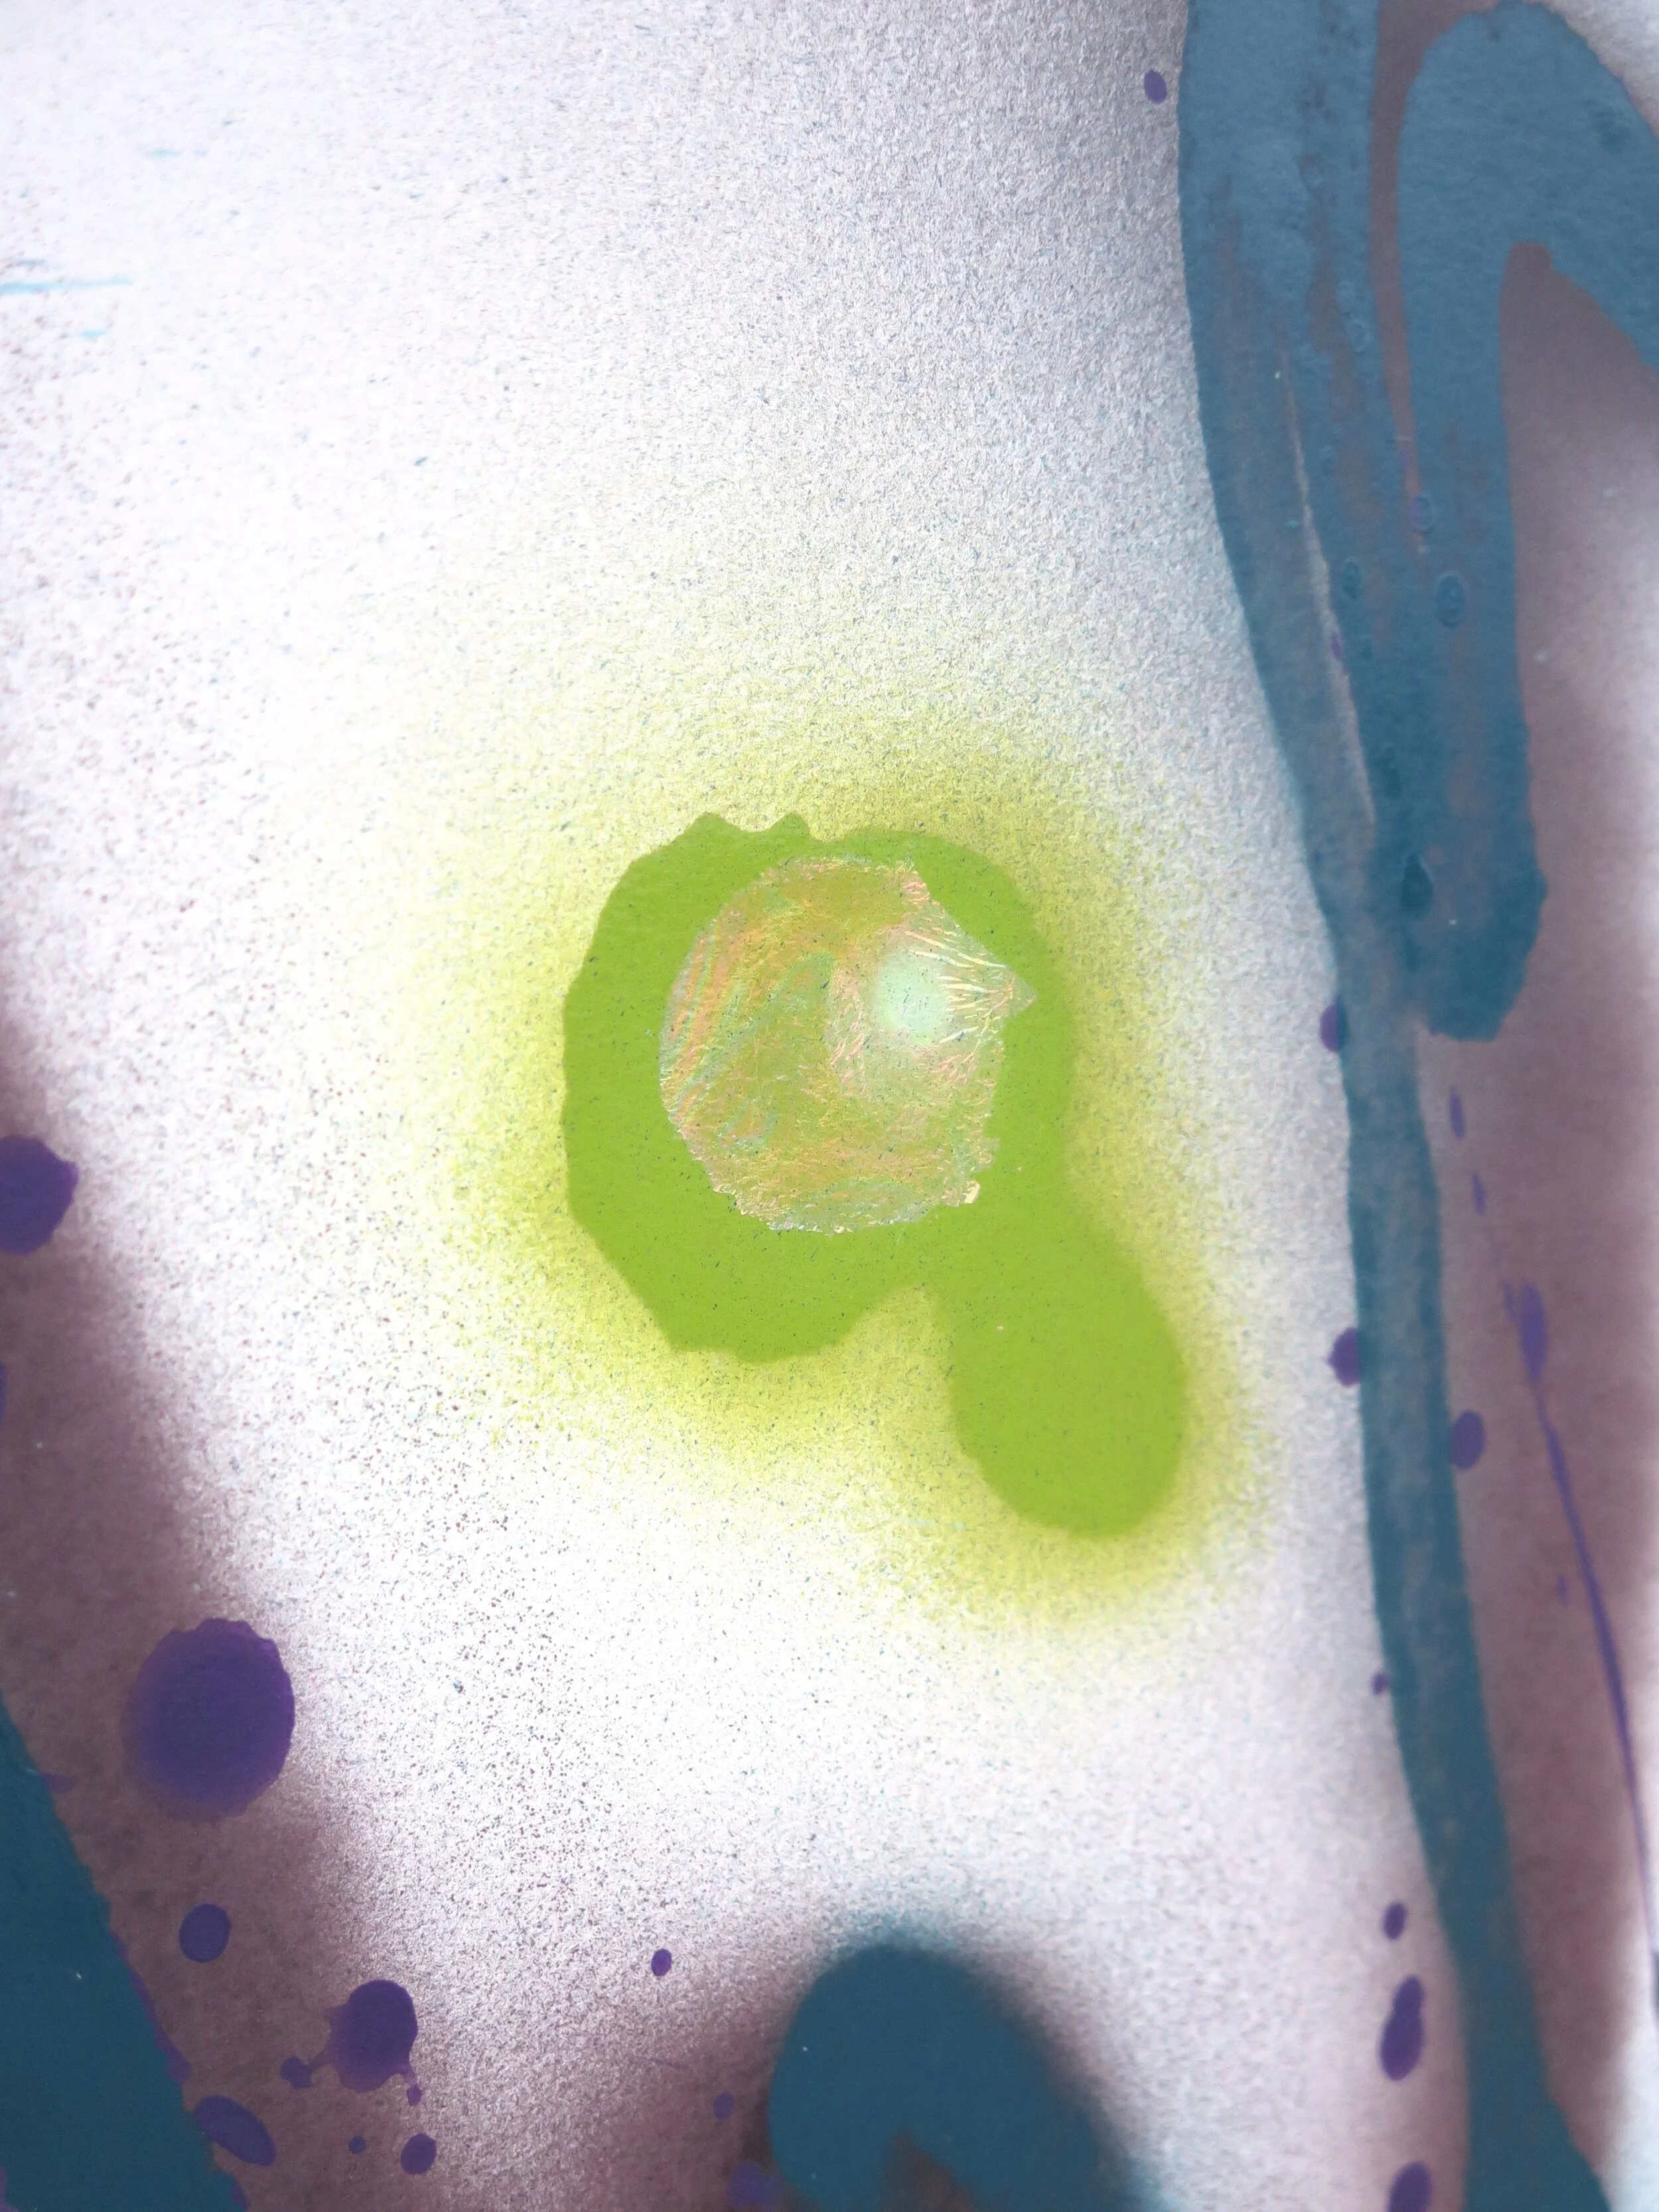
Charged 7 Detail b.JPG

Charged VII Triptych

Charged VII Triptych
$1,150.00
Triptych 3 Paper pieces each 24 x 18 Mixed Media Original Art Work on 140lb Water Color Paper
Work requires framing for display
May be mounted together in same frame or individually in separate frames
Color May vary from photo based on your monitor settings
Framing options available upon request
** Sizing in situation is approximate scale. Please check measurements of the work in relationship to your planned location.









